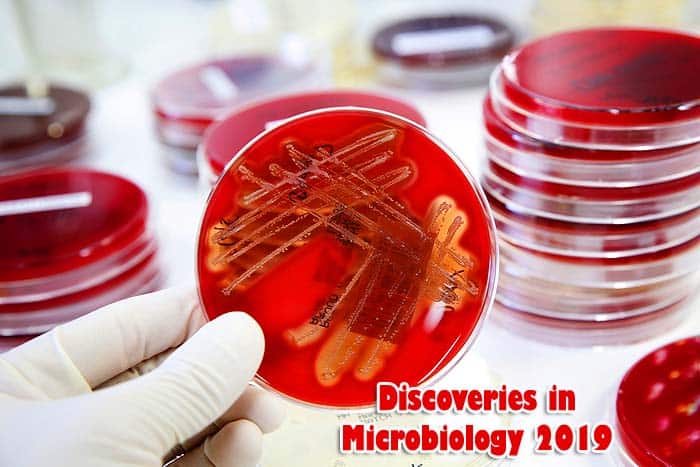
Latest Discoveries In Microbiology 2019

Order Escalloniales / Redclaws & Laurel Flowers
Escalloniales is an order of eudicotyledonous flowers placed under the clade of campanulidas. Being predominantly distributed in the southern hemisphere, Escalloniaceae plants possess simple, petiolate, exstipulate leaves, regular flowers mostly in racemose, and pentamerous floral parts. Redclaws, Chachacoma, Native laurel, Polyosmo leratii and white alder are among the beneficial Escalloniacea species.